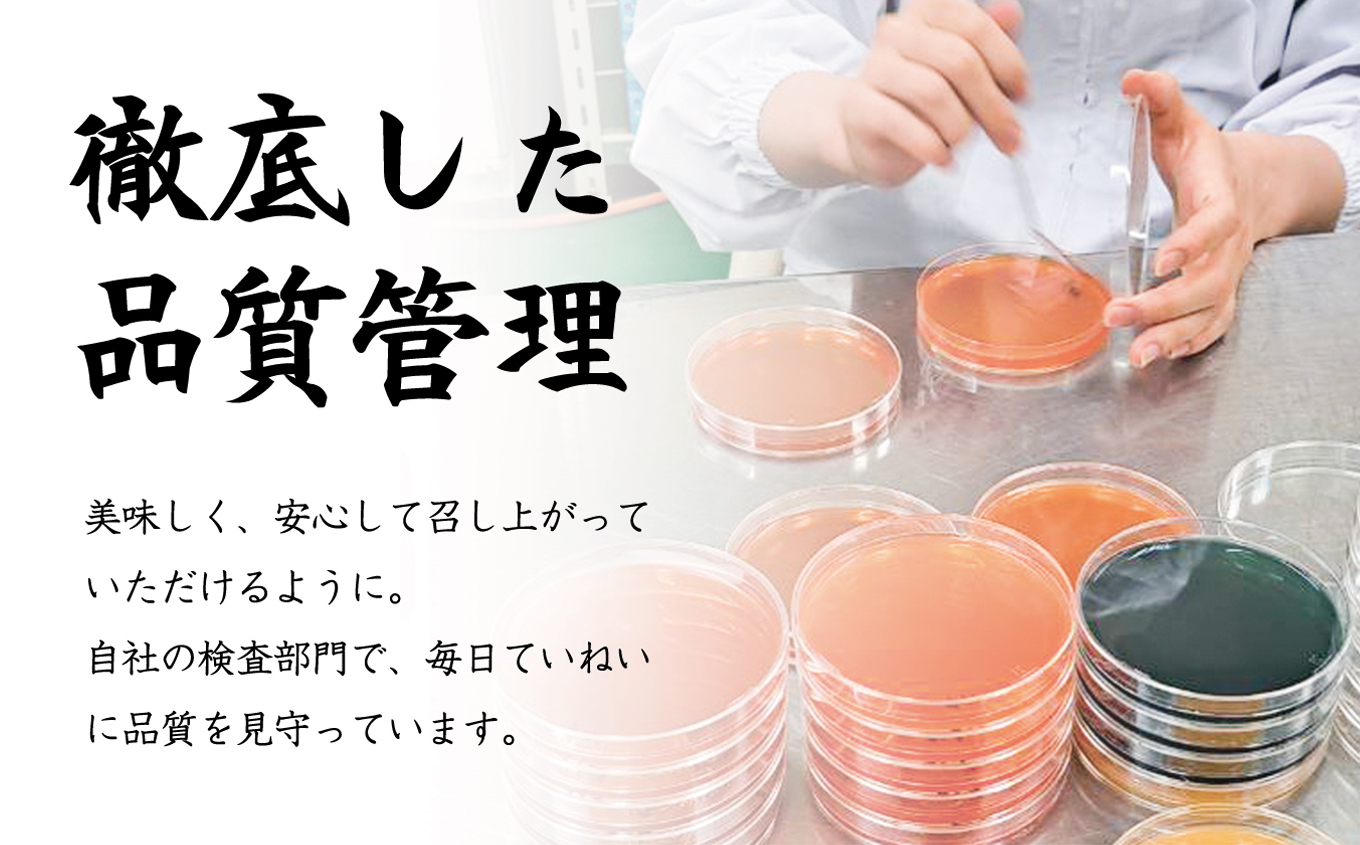
冷凍厚焼玉子　500g×2本入り｜卵 冷凍 卵焼き 厚焼玉子 和食 食品 おかず 伊那 長野県 信州【009-25】

-
- å·å
é·éç äŒé£åž
å·ååçŒçåã500gÃ2æ¬å ¥ãïœåµ å·å åµçŒã åçŒçå åé£ é£å ããã äŒé£ é·éç ä¿¡å·ã009-25ã
- 0.0
- (0)
å¯ééé¡ 9,000ååšåº«ãã- æ±ºæžæ¹æ³
- æ°é
-
è¿ç€Œåã®ç¹åŸŽ
å³ä»ãã¯çãã®å³ä»ãã§ãã ãããããŠããŸãã
嵿¥ããå€ãããªãå³ãå®ãç¶ããŠãããŸãã
äžå¯§ã«çŒãäžããåçŒãçåã¯ãæäœæ¥ã§åãäžããŠãããçŒãäžããåŸã«äžæ¬äžæ¬ååããã§ãã¯ããåæ Œããç©ã ããåºè·ããŠãããŸãã
500ïœãšå€§ãããµã€ãºã§ãã
è§£ååŸã«ã奜ããªåœ¢ã«ã«ãããã§ããæªè§£åãªãå·åã®ãŸãŸä¿åã§ããããã䜿ãããããªã£ãŠããŸãã
ãå
容éã
500ïœÃ2æ¬ã1ã»ãã
ãè³å³æéã
è£œé æ¥ãã1幎é
ãã¢ã¬ã«ã®ãŒã
åµã»ä¹³ã»å°éºŠã»å€§è±
ãã°ã»ããã»è±èã»é¶èã»ãŒã©ãã³
ããã®ä»ã
ã»-18â以äžã§ä¿åããŠäžããã
ã»èšèŒä»¥å€ã®è§£åæ¹æ³ã§è§£åããªãã§äžããã
ã»è§£ååŸã¯åœæ¥äžã«ãå¬ããããäžããã
ã»äžåºŠè§£åãããã®ã¯ååçµããªãã§äžããã
ãæ€çŽ¢ããŒã¯ãŒãã
嵿¥ä»¥æ¥å€ããã¬å³ èªç€Ÿè£œé åçŒãçå èªçæ¥ æå·»ãå¯¿åž ãã©ãã®æ¥ æ¡ãå¯¿åž ãåŒåœ ã ãå·»ãçå åµçŒããã€ãŸã¿ ãã〠æåç£ èŽãç© ã®ãã æ¿å
ãäºæ¥è
ã
æ ªåŒäŒç€Ÿãã€ã·ã¿ããŒãº
ã396-0215é·éçäŒé£åžé«é çºå°å540
åæµ·éåæ³åžã¯ãŒãã³å©çšå¯èœæœèšïŒäžäŸïŒ
| åæ³ã¹ããŒã·ã§ã³ããã« | http://www.chitose-sh.com/ |
|---|---|
| ããã«ãŠã£ã³ã°ã€ã³ã¿ãŒãã·ã§ãã«åæ³ | http://www.hotelwing.co.jp |
| ããã«ã°ã©ã³ãã©ã¹åæ³ | http://breezbay-group.com/hgt-chitose/ |
| åæ³ãšã¢ããŒãããã« | http://www.airport-hotel.co.jp |
| ããã€æ¹é¶Žé ãªãŸãŒãã¹ãæ°Žã®è¬ | http://www.mizunouta.com/ |
| æ¯ç¬æ¹ç¬¬äžå¯¶äºç ç¿ å±±äº | http://www.shikotsuko-daiichi.com/ |
| æ¹çã®å®¿æ¯ç¬æ¹ äžžé§æž©æ³æ 通 | https://www.marukoma.co.jp/ |
| ãšã¢ã¿ãŒããã«ããã« | http://www.air-terminal-hotel.jp/ |
| ãã«ãã ã€ã³ã¿ãŒãã·ã§ãã«åæµ·é | https://www.portom.jp/jp/ |
| ããã€æ¹é¶Žé å¥è 碧ã®åº§(åå£å³¶) | https://www.aonoza.com/ |
æºåžã»æºå®€çã®çç±ã«ãããæ€çŽ¢çµæç»é¢ãã«ãŠæœèšããã³å¯Ÿè±¡ãã©ã³ã衚瀺ãããªãå ŽåããããŸããããããããäºæ¿ãã ããã
æç¥çåå€å±åžã¯ãŒãã³å©çšå¯èœæœèšïŒäžäŸïŒ
| ããã«JALã·ãã£åå€å±ãéŠ | https://www.nagoya-nishiki.jalcity.co.jp/ |
|---|---|
| ããã³ãŒã¹ã¿ã€ã«åå€å± | https://nagoya.nikkostyle.jp/ |
| ã³ãŒãã€ãŒãã»ãã€ã»ããªãªããåå€å± | https://www.marriott.com/ja/hotels/ngocy-courtyard-nagoya/overview/ |
| åå€å±æ±æ¥ããã« | https://www.tokyuhotels.co.jp/nagoya-h/index.html |
| ãã€ã¯ãã€ãããããã«åå€å±é§ å | https://www.daiwaroynet.jp/nagoyaekimae/ |
| åå€å±æ ã¯ã·ã³ãã³ããã«ãã©ã¶ | http://washington.jp/sakae |
| ãã€ã¯ãã€ãããããã«åå€å±æ°å¹¹ç·å£ | http://www.daiwaroynet.jp/nagoya-shinkansenguchi/ |
| ããã«ãªãœã«åå€å± | https://www.resol-hotel.jp/nagoya/ |
| ãã«ãã³åå€å± | https://www.hiltonnagoya.com/ |
| äžäºã¬ãŒãã³ããã«åå€å±ãã¬ã㢠| http://www.gardenhotels.co.jp/nagoya-premier/ |
æºåžã»æºå®€çã®çç±ã«ãããæ€çŽ¢çµæç»é¢ãã«ãŠæœèšããã³å¯Ÿè±¡ãã©ã³ã衚瀺ãããªãå ŽåããããŸããããããããäºæ¿ãã ããã
åæµ·éæå·åžã¯ãŒãã³å©çšå¯èœæœèšïŒäžäŸïŒ
| OMO7æå· by æéãªãŸãŒã | https://omo-hotels.com/asahikawa/ |
|---|---|
| ã¢ãŒãããã«æå· | http://www.art-asahikawa.com/ |
| å€©ç¶æž©æ³ç¥åšã®æ¹¯ ããŒããŒã€ã³æå· | http://www.hotespa.net/hotels/asahikawa/ |
| å€©ç¶æž©æ³ãã¬ãã¢ããã«-CABIN-æå· | https://cabin.kenhotels.com/asahikawa/ |
| ã³ãŒãããã«æå· | http://www.courthotels.co.jp/asahikawa/ |
| ããã«ã¯ã¬ãã»ã³ãæå· | http://www.hotel-cr.com/ |
| æå·ããŒãšãŒããã« | http://toyo-hotel.net/ |
| JRã€ã³æå· | http://www.jr-inn.jp/asahikawa/ |
| ããã«ãŠã£ã³ã°ã€ã³ã¿ãŒãã·ã§ãã«æå·é§ å | https://www.hotelwing.co.jp/asahikawa/ |
| ããã«ã¢ããã¯æå· | https://amanekhotels.jp/asahikawa/ |
æºåžã»æºå®€çã®çç±ã«ãããæ€çŽ¢çµæç»é¢ãã«ãŠæœèšããã³å¯Ÿè±¡ãã©ã³ã衚瀺ãããªãå ŽåããããŸããããããããäºæ¿ãã ããã
ç¥å¥å·çè€æ²¢åžã¯ãŒãã³å©çšå¯èœæœèšïŒäžäŸïŒ
| ããã«æ³è¯ã¯ã©ãæ¹åã»è€æ²¢ | https://www.hokke.co.jp/shonan-fujisawa/ |
|---|---|
| çžéãã¬ããµã€ã³è€æ²¢æ¹åå° | https://sotetsu-hotels.com/fresa-inn/shonandai/ |
| æ±æšªINNæ¹åéåè€æ²¢é§ åå£ | https://www.toyoko-inn.com/index.php/search/detail/00115/ |
| ããã«ãŠã£ã³ã°ã€ã³ã¿ãŒãã·ã§ãã«æ¹åè€æ²¢ | https://www.hotelwing.co.jp/shonan-fujisawa/ |
| ã¹ãã€ã«ããã«æ¹åè€æ²¢ | https://smile-hotels.com/hotels/show/shonanfujisawa |
| ãããããã«æ¹åè€æ²¢ | https://kipphotel.com/ |
| ã¢ãããã«ãæ¹å 蟻å é§ åã | https://www.apahotel.com/hotel/syutoken/kanagawa/shonan-tsujido-ekimae/ |
æºåžã»æºå®€çã®çç±ã«ãããæ€çŽ¢çµæç»é¢ãã«ãŠæœèšããã³å¯Ÿè±¡ãã©ã³ã衚瀺ãããªãå ŽåããããŸããããããããäºæ¿ãã ããã
åæµ·é網走åžã¯ãŒãã³å©çšå¯èœæœèšïŒäžäŸïŒ
| ããã«ã«ãŒãã€ã³ç¶²èµ°é§ å | https://www.route-inn.co.jp/hotel_list/hokkaido/index_hotel_id_502/ |
|---|---|
| 網走ã»ã³ãã©ã«ããã« | http://www.abashirich.com |
| å倩ã®äžããã°ããæ¹é¶Žé ãªãŸãŒã | http://www.hokutennooka.com/ |
| ããã«ç¶²èµ°æ¹è | https://www.abashirikoso.com/ |
| 網走ãã€ã€ã«ããã« | http://abashiri-royal.jp/ |
| ãªãŒãã«ãžã¥åã®ææ | http://kitanodandan.com |
| ããã«ããªããŒãã¯ã»ã€ã³ | https://www.ohotsuku-inn.co.jp/ |
| ãããèã®é· èœåã®è ãããå± | http://www.kagariya.cc |
| ãã³ã·ã§ã³ããã«ã®å®¶ | https://waninoie.sakura.ne.jp |
| å€©ç¶æž©æ³ 倩éœã®æ¹¯ ããŒããŒã€ã³ç¶²èµ° | https://www.hotespa.net/hotels/abashiri/ |
æºåžã»æºå®€çã®çç±ã«ãããæ€çŽ¢çµæç»é¢ãã«ãŠæœèšããã³å¯Ÿè±¡ãã©ã³ã衚瀺ãããªãå ŽåããããŸããããããããäºæ¿ãã ããã
æ²çžçæ²çžåžã¯ãŒãã³å©çšå¯èœæœèšïŒäžäŸïŒ
| ãªããã¯ã°ã©ã³ã¡ãŒã«ãªãŸãŒã | https://www.okinawa-grandmer.com/ |
|---|---|
| ããã«ãã¥ãŒã»ã³ãã¥ãªãŒ | http://www.hotelnewcentury.co.jp/ |
| ã¯ã©ãŠã³ããã«æ²çž | https://crownhotel.jp |
| ãã€ãŽããã« | http://www.deigo.jp |
| ã¯ã©ãŠã³ããã«æ²çžã¢ããã¯ã¹ | https://crownhotel.jp |
| ã©ã€ã«ã ãã¡ããªãŒãªãŸãŒãããã«ïŒæ§ãã€ã°ã³ã©ãã€ãªãŸãŒãïŒ | https://www.hiyagun-lanairesort.jp/ |
| ããã«ã³ã¶ | https://hotel-koza.jp/ |
| ã¬ãæ²çžã¢ãªãŒãbyããã»ã«ããã«ãº | https://www.vessel-hotel.jp/ref/okinawa/ |
æºåžã»æºå®€çã®çç±ã«ãããæ€çŽ¢çµæç»é¢ãã«ãŠæœèšããã³å¯Ÿè±¡ãã©ã³ã衚瀺ãããªãå ŽåããããŸããããããããäºæ¿ãã ããã
å¥è¯çå¥è¯åžã¯ãŒãã³å©çšå¯èœæœèšïŒäžäŸïŒ
| ããã«æ¥èªå¥è¯ | https://www.nikkonara.jp/ |
|---|---|
| ã³ã³ãã©ãŒãããã«å¥è¯ | https://www.choice-hotels.jp/hotel/nara/ |
| ããã«å°Ÿè± | https://obana.nara.jp |
| å¥è¯ã¯ã·ã³ãã³ããã«ãã©ã¶ | https://www.washingtonhotel.co.jp/whp/nara/ |
| å¥è¯ããŒã¯ããã« | https://www.narapark.jp/ |
| æ¥æ¥ããã« | https://www.kasuga-hotel.co.jp/ |
| å€©ç¶æž©æ³ åéæ¡ã®æ¹¯ 埡宿éä¹å¥è¯ | https://dormy-hotels.com/dormyinn/hotels/nono_nara/ |
| JWããªãªããã»ããã«å¥è¯ | https://www.marriott.com/ja/hotels/osajw-jw-marriott-hotel-nara/overview/ |
| ãã€ã¯ãã€ãããããã«å¥è¯ | https://www.daiwaroynet.jp/nara/ |
| ãããã«å¥è¯ | https://www.novotelnara.com/ |
æºåžã»æºå®€çã®çç±ã«ãããæ€çŽ¢çµæç»é¢ãã«ãŠæœèšããã³å¯Ÿè±¡ãã©ã³ã衚瀺ãããªãå ŽåããããŸããããããããäºæ¿ãã ããã
é·åŽçäœäžä¿åžã¯ãŒãã³å©çšå¯èœæœèšïŒäžäŸïŒ
| ããã«æ¥èªããŠã¹ãã³ãã¹ | http://www.nikko-htb.co.jp |
|---|---|
| äœäžä¿ã¯ã·ã³ãã³ããã« | http://www.sasebohotel.com |
| ããã«ãšãŒããã ããŠã¹ãã³ãã¹ | https://www.huistenbosch.co.jp/hotels/he/ |
| ããã«ãªãœã«äœäžä¿ | https://www.resol-hotel.jp/sasebo/ |
| ãã©ã¬ã¹ããŽã£ã© ããŠã¹ãã³ãã¹ | https://www.huistenbosch.co.jp/hotels/fv/ |
| ããã«ã¢ã ã¹ãã«ãã ããŠã¹ãã³ãã¹ | https://www.huistenbosch.co.jp/hotels/am/index |
| åŒåŒµã®äžããã« | http://www.yumihari.com/ |
| ããã«ãã³ããŒã° ããŠã¹ãã³ãã¹ | https://www.huistenbosch.co.jp/hotels/hd/ |
| ããã«ãªãŒã¯ã©JRããŠã¹ãã³ãã¹ | https://www.jrhtb.hotelokura.co.jp |
| ããã«ãããã«ãã ããŠã¹ãã³ãã¹ | https://www.huistenbosch.co.jp/hotels/hr/ |
æºåžã»æºå®€çã®çç±ã«ãããæ€çŽ¢çµæç»é¢ãã«ãŠæœèšããã³å¯Ÿè±¡ãã©ã³ã衚瀺ãããªãå ŽåããããŸããããããããäºæ¿ãã ããã
èšåçã¯ãŒãã³å©çšå¯èœæœèšïŒäžäŸïŒ
| ããã«æ¥èªã€ãã° | https://www.nikko-tsukuba.com/ |
|---|---|
| ããã«JALã·ãã£ã€ãã° | https://www.tsukuba.hoteljalcity.com/ |
| ãã€ã¯ãã€ãããããã«ã€ãã° | http://www.daiwaroynet.jp/tsukuba/ |
| ãã€ã¯ãã€ãããããã«æ°Žæž | https://www.daiwaroynet.jp/mito/ |
| ããã«ãŠã£ã³ã°ã€ã³ã¿ãŒãã·ã§ãã«æ¥ç« | http://www.hotelwing.co.jp/hitachi/ |
| JRæ±æ¥æ¬ããã«ã¡ãã æ°ŽæžïŒæ§ããã«ã¡ããæ°ŽæžïŒ | https://www.hotelmets.jp/mito/ |
| ããã«ãšãªã¢ã¯ã³æ±æµ· | https://www.hotel-areaone.com/tokai/ |
| ããã«ãšãªã¢ã¯ã³åèšå | https://www.hotel-areaone.com/kitaibaraki/ |
| å€©ç¶æž©æ³ éŠæ¢ ã®æ¹¯ ããŒããŒã€ã³æ°Žæž | https://dormy-hotels.com/dormyinn/hotels/mito/ |
| ã¶ã»ã»ã¬ã¯ãã³åæµŠé§ å | https://celecton.com/tsuchiura |
æºåžã»æºå®€çã®çç±ã«ãããæ€çŽ¢çµæç»é¢ãã«ãŠæœèšããã³å¯Ÿè±¡ãã©ã³ã衚瀺ãããªãå ŽåããããŸããããããããäºæ¿ãã ããã
æ æšçæ¥å åžã¯ãŒãã³å©çšå¯èœæœèšïŒäžäŸïŒ
| ããã«ãããã¥ã©ã«ã¬ãŒãã³æ¥å | https://www.n-garden-hotel.com/ |
|---|---|
| ããã«ã«ãžã¥ã¢ã«ãŠãŒã | http://www.nikko-casual.jp |
| 鬌æå·ãä»çå°ãã©ã¶ | https://www.niousonplaza.com/ |
| 鬌æå·æž©æ³ãããã | http://www.asaya-hotel.co.jp/ |
| æ¥å éè°·ããã« | http://www.kanayahotel.co.jp/nkh/ |
| æ¥å ãã¬å·ããã«äžæ¥æ | https://www.mikazuki.co.jp/kinugawa/ |
| 鬌æå·ãã©ã¶ããã« | https://www.kinugawa.co.jp/plaza/ |
| äºã®äºãã㫠奥æ¥å 湯å | https://kamenoi-hotels.com/en/okunikko/ |
| äºã®äºããã« æ¥å æ¹¯è¥¿å· ãªãŒã«ã€ã³ã¯ã«ãŒã·ãããã« | https://kamenoi-hotels.com/nikkoyunishigawa/ |
æºåžã»æºå®€çã®çç±ã«ãããæ€çŽ¢çµæç»é¢ãã«ãŠæœèšããã³å¯Ÿè±¡ãã©ã³ã衚瀺ãããªãå ŽåããããŸããããããããäºæ¿ãã ããã
山圢ç山圢åžã¯ãŒãã³å©çšå¯èœæœèšïŒäžäŸïŒ
| ãªããã¢ã³ãããã«å±±åœ¢é§ å | https://richmondhotel.jp/yamagata/ |
|---|---|
| ããã«ã¡ããããªã¿ã³å±±åœ¢ | https://yamagata.metropolitan.jp/ |
| å±±åœ¢é§ è¥¿å£ã¯ã·ã³ãã³ããã« | http://washington-hotels.jp/yamagata-ekinishiguchi/ |
| JURIN | https://zao-jurin.com/ |
| åæ¹¯ãªãŸãŒã ã«ãŒã»ã³ãã¿ã«ã〠| http://www.zao.co.jp/lucent/ |
| ããã¿ãç çå¶æ¥œãªãŸãŒã | http://www.zao.co.jp/rurikura/ |
| ããã«åãã | http://www.zao-kiraku.co.jp/ |
| èµçãã©ã¶ããã« | http://www.zao-plaza.com/ |
| åæ¹¯è åµ | https://www.meitoya.com/ |
| ãã€ã¯ãã€ãããããã«å±±åœ¢é§ å | https://www.daiwaroynet.jp/yamagata-ekimae/ |
æºåžã»æºå®€çã®çç±ã«ãããæ€çŽ¢çµæç»é¢ãã«ãŠæœèšããã³å¯Ÿè±¡ãã©ã³ã衚瀺ãããªãå ŽåããããŸããããããããäºæ¿ãã ããã
æ²çžç糞æºåžã¯ãŒãã³å©çšå¯èœæœèšïŒäžäŸïŒ
| ãµã¶ã³ããŒãããã«ïŒãªãŸãŒãæ²çž | https://www.southernbeach-okinawa.com/ |
|---|---|
| ççããã«ïŒãªãŸãŒã ååããŒã | https://ryukyuhotel.kenhotels.com/ |
æºåžã»æºå®€çã®çç±ã«ãããæ€çŽ¢çµæç»é¢ãã«ãŠæœèšããã³å¯Ÿè±¡ãã©ã³ã衚瀺ãããªãå ŽåããããŸããããããããäºæ¿ãã ããã
å®®åçä»å°åžã¯ãŒãã³å©çšå¯èœæœèšïŒäžäŸïŒ
| ããã«JALã·ãã£ä»å° | http://www.sendai.jalcity.co.jp/ |
|---|---|
| ããã«ã¢ã³ãã¬ä»å° | http://www.hotelmonterey.co.jp/sendai/ |
| ä»å°åœéããã« | http://www.tobu-skh.co.jp/ |
| ãã€ã¯ãã€ãããããã«ä»å° | https://www.daiwaroynet.jp/sendai/ |
| ããã«ã¡ããããªã¿ã³ä»å° | https://sendai.metropolitan.jp/ |
| äžäºã¬ãŒãã³ããã«ä»å° | http://www.gardenhotels.co.jp/sendai/ |
| ãŠã§ã¹ãã£ã³ããã«ä»å° | https://the-westin-sendai.com/ |
| ç§ä¿ã°ã©ã³ãããã« | http://www.akiugrand.com/ |
| è¶å¯®ãå®å | https://saryo-souen.com/ |
| ä»å°ã»ç§ä¿æž©æ³ãç¯ç«ã®æ¹¯ãç·æ°Žäº | http://www.ryokusuitei.co.jp/ |
æºåžã»æºå®€çã®çç±ã«ãããæ€çŽ¢çµæç»é¢ãã«ãŠæœèšããã³å¯Ÿè±¡ãã©ã³ã衚瀺ãããªãå ŽåããããŸããããããããäºæ¿ãã ããã
å µåº«çç¥æžåžã¯ãŒãã³å©çšå¯èœæœèšïŒäžäŸïŒ
| ç¥æžã¡ãªã±ã³ããŒã¯ãªãªãšã³ã¿ã«ããã« | http://www.kobe-orientalhotel.co.jp/ |
|---|---|
| ããã«ãªãŒã¯ã©ç¥æž | https://www.kobe.hotelokura.co.jp/ |
| ç¥æžãã€ã·ã§ã©ãã³ããã«ïŒã¿ã¯ãŒãº | http://www.sheraton-kobe.co.jp/ |
| ããã«ã¢ã³ãã¬ç¥æž | http://www.hotelmonterey.co.jp/kobe/ |
| ç¥æžããŒããã¢ããã« | https://www.portopia.co.jp/ |
| ããã«ããŒã«ã·ãã£ç¥æž | https://hmihotelgroup.com/pearlcity-kobe/ |
| ORIENTAL HOTEL(ãªãªãšã³ã¿ã«ããã«) | http://www.orientalhotel.jp/ |
| ããã«ã¯ã©ãŠã³ãã¬ã¹ç¥æž | https://hmihotelgroup.com/crownpalais-kobe/ |
| ããã«ãã©ã»ã¹ã€ãŒãç¥æžããŒããŒã©ã³ã | https://www.l-s.jp/ |
| ãã©ãŒãã€ã³ã ãã¬ãã¯ã¹ by ã·ã§ã©ãã³ ç¥æžäžå®® | https://www.marriott.com/ja/hotels/ukbxf-four-points-flex-kobe-sannomiya/overview/ |
æºåžã»æºå®€çã®çç±ã«ãããæ€çŽ¢çµæç»é¢ãã«ãŠæœèšããã³å¯Ÿè±¡ãã©ã³ã衚瀺ãããªãå ŽåããããŸããããããããäºæ¿ãã ããã
åºå³¶çåºå³¶åžã¯ãŒãã³å©çšå¯èœæœèšïŒäžäŸïŒ
| ã·ã§ã©ãã³ã°ã©ã³ãããã«åºå³¶ | https://www.marriott.com/ja/hotels/hijsi-sheraton-grand-hiroshima-hotel/overview/ |
|---|---|
| äžäºã¬ãŒãã³ããã«åºå³¶ | http://www.gardenhotels.co.jp/hiroshima/ |
| ããã«ã°ã©ã³ãŽã£ã¢åºå³¶ | http://www.hgh.co.jp/ |
| ã°ã©ã³ãããªã³ã¹ããã«åºå³¶ | http://www.princehotels.co.jp/hiroshima/ |
| ãªãŒã¬ãã€ã€ã«ããã«åºå³¶ | http://www.rihga.co.jp/hiroshima/index.html |
| ãªãªãšã³ã¿ã«ããã«åºå³¶ | https://oriental-hiroshima.com/ |
| åºå³¶ã¯ã·ã³ãã³ããã« | http://washington-hotels.jp/hiroshima/ |
| ã¶ããã€ã€ã«ããŒã¯ããã«åºå³¶ãªããŒãµã€ã | https://www.the-royalpark.jp/the/hiroshimars/ |
| ããã«ã€ã³ã¿ãŒã²ãŒãåºå³¶ | https://www.intergatehotels.jp/hiroshima/ |
| ãã«ãã³åºå³¶ | https://hiroshima.hiltonjapan.co.jp/ |
æºåžã»æºå®€çã®çç±ã«ãããæ€çŽ¢çµæç»é¢ãã«ãŠæœèšããã³å¯Ÿè±¡ãã©ã³ã衚瀺ãããªãå ŽåããããŸããããããããäºæ¿ãã ããã
岩æçç岡åžã¯ãŒãã³å©çšå¯èœæœèšïŒäžäŸïŒ
| ã¯ã·ã³ãã³ïŒ²ïŒïŒ¢ããã«çå²¡é§ å | https://www.washingtonhotel.co.jp/rb/morioka/ |
|---|---|
| ãã€ã¯ãã€ãããããã«ç岡 | http://www.daiwaroynet.jp/morioka/ |
| ããã«ããŒã«ã·ãã£ç岡 | https://hmihotelgroup.com/pearlcity-morioka/ |
| ã¢ãŒãããã«ç岡 | http://art-morioka.com/ |
| ããã«ã¡ããããªã¿ã³ç岡 | https://morioka.metropolitan.jp/ |
| ã€ãªãæž©æ³ ããã«çŽ«è | http://www.hotel-shion.com/ |
| åããã« | http://www.kitahotel.jp |
| ãã©ãŒãã€ã³ã ãã¬ãã¯ã¹ by ã·ã§ã©ãã³ ç岡 | https://www.marriott.com/ja/hotels/hnamu-four-points-flex-morioka/overview/ |
| ãã€ã¯ãã€ãããããã«çå²¡é§ å | https://www.daiwaroynet.jp/morioka-ekimae/ |
| ãªããã¢ã³ãããã«çå²¡é§ å | https://richmondhotel.jp/morioka/ |
æºåžã»æºå®€çã®çç±ã«ãããæ€çŽ¢çµæç»é¢ãã«ãŠæœèšããã³å¯Ÿè±¡ãã©ã³ã衚瀺ãããªãå ŽåããããŸããããããããäºæ¿ãã ããã
åæµ·éå¯è¯éåžã¯ãŒãã³å©çšå¯èœæœèšïŒäžäŸïŒ
| æ°å¯è¯éããªã³ã¹ããã« | http://www.princehotels.co.jp/newfurano/ |
|---|---|
| ãã | http://www.natulux.com/ |
| ãªãŸãŒãã€ã³ãããŒã¹ã«ã³ããªãŒ | http://www.north-country.co.jp/ |
| ããã«ããã¥ãŒã«ãŽã¡ã«ãå¯è¯é | http://naturwald-furano.com/ |
| ããã«ã»ãã«ãã«ãº | http://www.bellhills.jp/ |
| å¯è¯éãªãŸãŒãããã«ããšãŒãã«ãŽã§ã«ã¡ | http://www.edelwarme.jp/ |
| ããã«ã ãã³å¯è¯é(Hotel Munin Furano) | https://www.hotelmunin.com/ |
| å€©ç¶æž©æ³ã玫é²ã®æ¹¯ãã©ãã¹ã¿å¯è¯éãã«ãº | https://www.hotespa.net/hotels/furano/ |
| ã¯ã€ããªãŒããã«ïŒã³ã³ãããã¢ã äžè± | https://hotel-hitohana.com/ |
| Nozo Hotel | https://nozohotel.com/ |
æºåžã»æºå®€çã®çç±ã«ãããæ€çŽ¢çµæç»é¢ãã«ãŠæœèšããã³å¯Ÿè±¡ãã©ã³ã衚瀺ãããªãå ŽåããããŸããããããããäºæ¿ãã ããã
åæµ·éæŽçºæ¹çºã¯ãŒãã³å©çšå¯èœæœèšïŒäžäŸïŒ
| æŽçºæ¹äžäžé£ ããã«ã¬ã€ã¯ãµã€ããã©ã¹ | https://www.toyamanseikaku.jp/ |
|---|---|
| æŽçºèгå ããã« | http://www.toyakanko.com/ |
| çµ¶æ¯ã®æ¹¯å®¿ãæŽçºæ¹çäº | http://www.toya-kohantei.com/ |
| ããã«ã°ã©ã³ãããŒã€ | http://www.grandtoya.com |
| ããšããæŽçºæ¹ | https://yutorelo-toyako.com/ |
| ã¶ã»ãŠã£ã³ã¶ãŒããã«æŽçºãªãŸãŒãïŒã¹ã | http://www.windsor-hotels.co.jp/ |
| ã¶ãã¬ã€ã¯ãã¥ãŒããä¹ã®é¢šãªãŸãŒã | http://nonokaze-resort.com/ |
| WE Hotel Toya | https://wehoteltoya.com |
| HOTEL COCOA RESORT | https://cocoaresort.jp/ |
æºåžã»æºå®€çã®çç±ã«ãããæ€çŽ¢çµæç»é¢ãã«ãŠæœèšããã³å¯Ÿè±¡ãã©ã³ã衚瀺ãããªãå ŽåããããŸããããããããäºæ¿ãã ããã
åèçæµŠå®åžã¯ãŒãã³å©çšå¯èœæœèšïŒäžäŸïŒ
| ãã«ãã³æ±äº¬ã〠| https://tokyobay.hiltonjapan.co.jp/ |
|---|---|
| ãªãªãšã³ã¿ã«ããã«æ±äº¬ã〠| http://www.oriental-hotel.co.jp/ |
| æ±äº¬ãã€èæµããã« | http://www.maihamahotel.jp/ |
| æ±äº¬ãã€èæµããã«ããã¡ãŒã¹ããªãŸãŒã | https://www.maihamahotel-firstresort.jp/ |
| ã·ã§ã©ãã³ã»ã°ã©ã³ãã»ããŒãã§ãŒãã€ã»ããã« | https://www.marriott.com/ja/hotels/tyosi-sheraton-grande-tokyo-bay-hotel/overview/ |
| ããã«ãªãŒã¯ã©æ±äº¬ã〠| http://www.okuratokyobay.net/ |
| äžäºã¬ãŒãã³ããã«ãã©ãæ±äº¬ã〠| https://www.gardenhotels.co.jp/prana-tokyobay/ |
| 浊å®ãã©ã€ãã³ããã«æ±äº¬ã〠| https://urayasu.brightonhotels.co.jp/index.html |
| ããã« ãšããªã³ æ±äº¬ã〠| http://www.hotel-emion.jp/ |
| ã°ã©ã³ãããã³ãŒæ±äº¬ãã€ èæµ | https://tokyobay.grandnikko.com/ |
| æ±äº¬ãã£ãºããŒã©ã³ãïŒïŒ²ïŒããã« | https://www.tokyodisneyresort.jp/hotel/tdh.html |
| æ±äº¬ãã£ãºããŒã·ãŒã»ããã«ãã©ã³ã¹ã¿ïŒïŒ²ïŒ | https://www.tokyodisneyresort.jp/hotel/dhm.html |
| ãã£ãºããŒã¢ã³ããµããŒïŒïŒ²ïŒããã« | https://www.tokyodisneyresort.jp/hotel/dah.html |
| æ±äº¬ãã£ãºããŒã»ã¬ãã¬ãŒã·ã§ã³ããã«ïŒïŒ²ïŒ | https://www.tokyodisneyresort.jp/hotel/dch.html |
| æ±äº¬ãã£ãºããŒãªãŸãŒãã»ãã€ã»ã¹ããŒãªãŒRããã« | https://www.tokyodisneyresort.jp/hotel/tsh.html |
| æ±äº¬ãã£ãºããŒã·ãŒã»ãã¡ã³ã¿ãžãŒã¹ããªã³ã°ã¹ããã« | https://www.tokyodisneyresort.jp/hotel/fsh.html |
æºåžã»æºå®€çã®çç±ã«ãããæ€çŽ¢çµæç»é¢ãã«ãŠæœèšããã³å¯Ÿè±¡ãã©ã³ã衚瀺ãããªãå ŽåããããŸããããããããäºæ¿ãã ããã
çŠå²¡ççŠå²¡åžã¯ãŒãã³å©çšå¯èœæœèšïŒäžäŸïŒ
| ããã«æ¥èªçŠå²¡ | http://www.hotelnikko-fukuoka.com/ |
|---|---|
| å倿±æ¥ïŒ²ïŒ¥ïŒ©ããã« | https://www.tokyuhotels.co.jp/hakata-r/ |
| ããã«ã¢ã³ãã¬ãã©ã»ã¹ãŒã«çŠå²¡ | https://www.hotelmonterey.co.jp/lasoeur_fukuoka/ |
| åå€ãšã¯ã»ã«ããã«æ±æ¥ | https://www.tokyuhotels.co.jp/hakata-e/ |
| ãœã©ãªã¢è¥¿éããã«çŠå²¡ | https://nnr-h.com/solaria/fukuoka/ |
| 西éã°ã©ã³ãããã« | https://nnr-h.com/grandhotel/ |
| JRä¹å·ããã«ããã©ããµã çŠå²¡ | https://www.jrk-hotels.co.jp/Fukuoka/ |
| ããã«ãã¢ã³ãããšã«ããŒãçŠå²¡ | https://www.monte-hermana.jp/fukuoka/ |
| ããã«ã¢ã³ãã¬çŠå²¡ | https://www.hotelmonterey.co.jp/fukuoka/ |
| ããã«JALã·ãã£çŠå²¡ å€©ç¥ | https://www.fukuoka-tenjin.hoteljalcity.com/ |
æºåžã»æºå®€çã®çç±ã«ãããæ€çŽ¢çµæç»é¢ãã«ãŠæœèšããã³å¯Ÿè±¡ãã©ã³ã衚瀺ãããªãå ŽåããããŸããããããããäºæ¿ãã ããã
京éœåºäº¬äž¹åŸåžã¯ãŒãã³å©çšå¯èœæœèšïŒäžäŸïŒ
| æµ·è±äºãè±åŸ¡å | https://www.kaikatei.net/ |
|---|---|
| è²äºæž©æ³ããã£ãºã庵 | https://www.1-pen.net/ |
| é¢ãã®å®¿ã忥œ | https://www.waraku-yado.jp/ |
| ãªãŸãŒãã¢ä¹ çŸæµ | https://www.rtg.jp/hotels/smc/kumi/ |
| KISSUIEN StayïŒFood | https://kissuien.jp/ |
| å®å·æž©æ³ããéã®é | https://ukawaonsen.jp |
| ããã«äž¹åŸçåœ | https://www.hotel-tango-kingdom.com/ |
| æçæ é€šå€æ¥ã¶æµŠ | https://www.yuuhigaura.com/ |
| ç¢§ç¿ åŸ¡è | http://hekisui.jp/ |
| ã»ã³ãã©ãŒã¬ã»ããã«äº¬äž¹åŸ | https://www.centrale.co.jp/ |
æºåžã»æºå®€çã®çç±ã«ãããæ€çŽ¢çµæç»é¢ãã«ãŠæœèšããã³å¯Ÿè±¡ãã©ã³ã衚瀺ãããªãå ŽåããããŸããããããããäºæ¿ãã ããã
ç¥å¥å·çå·åŽåžã¯ãŒãã³å©çšå¯èœæœèšïŒäžäŸïŒ
| å·åŽæ¥èªããã« | https://www.kawasaki-nikko-hotel.com |
|---|---|
| çžéãã¬ããµã€ã³ å·åŽé§ æ±å£ | https://sotetsu-hotels.com/fresa-inn/kawasaki/ |
| ãªããã¢ã³ãããã«ãã¬ãã¢æŠèµå°æ | http://richmondhotel.jp/musashikosugi/ |
| JRæ±æ¥æ¬ããã«ã¡ãã å·åŽïŒæ§ããã«ã¡ããå·åŽïŒ | http://www.hotelmets.jp/kawasaki/ |
| ãã€ã¯ãã€ãããããã«å·åŽ | https://www.daiwaroynet.jp/kawasaki/ |
| JRæ±æ¥æ¬ããã«ã¡ãã æºãå£ïŒæ§ããã«ã¡ããæºãå£ïŒ | https://www.hotelmets.jp/mizonokuchi/ |
| 京æ¥ïŒ¥ïŒžã€ã³ 京æ¥å·åŽé§ å | https://www.keikyu-exinn.co.jp/hotel/kawasaki/ |
| å·åŽãã³ã°ã¹ã«ã€ããã³ã æ±æ¥REIããã« | https://www.tokyuhotels.co.jp/kawasaki-r/ |
| ããã«ã¡ããããªã¿ã³å·åŽ | https://kawasaki.metropolitan.jp/ |
| å€©ç¶æž©æ³ ææµã®æ¹¯ ããŒããŒã€ã³å·åŽ | https://www.hotespa.net/hotels/kawasaki/ |
æºåžã»æºå®€çã®çç±ã«ãããæ€çŽ¢çµæç»é¢ãã«ãŠæœèšããã³å¯Ÿè±¡ãã©ã³ã衚瀺ãããªãå ŽåããããŸããããããããäºæ¿ãã ããã
è¿ç€Œå詳现
-
æäŸå ãBHãæ ªåŒäŒç€Ÿãã€ã·ã¿ããŒãº é é å·å é éæ³šèš ãé 鿥ã
çšæãæŽãæ¬¡ç¬¬ãå·åã«ãŠçºéããããŸãã
çºéãŸã§1ãæã»ã©ã®ãæéãé æŽããŸãã
é éæ¥ã®æå®ã¯ã§ããŸããããå±ãäºå®æ¥ã«é¢ããåå¥ã®ãåãåããã¯ãé æ ®ãã ããã
ååæé垯ã®åžæãããããŸããããåèæ¬ã«èšå ¥ããé¡ãããŸãã
ãçºéã«ã€ããŠã
â»ãå±ãæ¥ã®æå®ã¯ã§ããŸããã®ã§ããäºæ¿ãã ããã
â»é·æäžåšã®ãäºå®ãããã°äºåå±ãžãé£çµ¡ãã ããã
â»å°ãé·æäžåšçã«ããã瀌ã®åããååãã§ããªãã£ãå Žåãåçºéã¯ã§ããŸãããããããããäºæ¿ãã ããã
â»é 鿥è ã¯ã€ããé茞ãšãªããŸãã®ã§ãé éé£çµ¡ããåžæã®æ¹ã¯ãã¯ããã³ã¡ã³ããŒãºã®å å ¥ããå§ãããããŸãã
â»è¿ç€Œåã®é éå äœæã«å€æŽããã£ãå Žåã«ã¯ãéããã«äºåå±ãŸã§ãé£çµ¡ãã ããã
â»çºéå¯èœææã«ãªããçºéããããšããå¯éæã«ç»é²ããã¡ãŒã«ã¢ãã¬ã¹ã«ãåºè·å®äºã¡ãŒã«ããå±ããŸãã
â»çºéåŸã®å Žåã¯ãçŽæ¥ãé 鿥è ã«ãåãåãããã ããã
â»è»¢éæéããããå Žåã¯å¯éè æ§ã®ãè² æ ãšãªããŸãã
-
å 容é 500ïœÃ2æ¬ã1ã»ãã è³å³æé è£œé æ¥ãã1幎é è¿ç€Œåæ³šèš ã¢ã¬ã«ã®ãŒïŒåµãä¹³æåãå°éºŠããã°ããããè±èãé¶èããŒã©ãã³ã倧è±ãããŸãã
è¿ç€Œåã®ææ³
ææ³ã¯ãŸã ãããŸããã